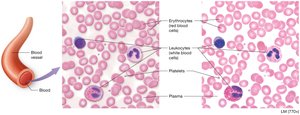
Microscopic view of blood showing erythrocytes, leukocytes, and platelets

Back
BackChapter 19: Blood – Structure, Function, and Clinical Relevance
Study Guide - Smart Notes

Blood: Overview and Functions
Introduction to Blood
Blood is a specialized fluid connective tissue essential for transporting substances throughout the body and maintaining homeostasis. It consists of formed elements (cells and cell fragments) suspended in a nonliving fluid matrix called plasma.
Formed elements: Erythrocytes (red blood cells), leukocytes (white blood cells), and platelets (thrombocytes).
Plasma: The liquid component, making up about 55% of blood volume.
Hematocrit: The percentage of blood volume occupied by erythrocytes (typically 40–50% in males, 36–44% in females).
Functions of Blood
Gas exchange: Transports oxygen (O2) and carbon dioxide (CO2).
Distribution of solutes: Delivers nutrients, hormones, and waste products.
Immune defense: Circulates leukocytes and immune proteins.
Thermoregulation: Distributes heat generated by metabolism.
Clotting: Platelets and proteins form clots to prevent blood loss.
Acid-base homeostasis: Maintains blood pH (7.35–7.45) via buffering systems.
Blood pressure regulation: Blood volume is a major determinant of blood pressure.
Composition of Blood
Plasma
Plasma is the nonliving, straw-colored fluid matrix of blood, comprising about 90% water and 10% dissolved solutes.
Plasma Component | Function |
|---|---|
Water | Solvent for carrying substances; absorbs heat |
Plasma Proteins (Albumin, Fibrinogen, Globulins) | Osmotic balance, pH buffering, clotting, defense, and transport |
Salts (Electrolytes) | Osmotic balance, pH buffering, membrane permeability |
Nutrients | Glucose, fatty acids, amino acids, vitamins |
Waste Products | Urea, uric acid |
Respiratory Gases | O2 and CO2 |
Hormones | Transported by plasma proteins |

Formed Elements
The formed elements include erythrocytes, leukocytes, and platelets. These cells are produced in the red bone marrow through a process called hematopoiesis.
Erythrocytes (RBCs): Transport oxygen and carbon dioxide.
Leukocytes (WBCs): Defend against pathogens.
Platelets: Involved in blood clotting.

Hematopoiesis and Erythropoiesis
Hematopoiesis
Hematopoiesis is the process of blood cell formation, occurring primarily in red bone marrow. All blood cells originate from hematopoietic stem cells (HSCs), which differentiate into myeloid and lymphoid lineages.
Lymphoid stem cells: Give rise to lymphocytes (B cells, T cells, NK cells).
Myeloid stem cells: Produce erythrocytes, platelets, and other leukocytes.
Erythropoiesis
Erythropoiesis is the formation of red blood cells. It is regulated by erythropoietin (EPO), a hormone produced by the kidneys in response to low blood oxygen levels.
HSCs differentiate into erythrocyte colony-forming units (CFUs).
CFUs become proerythroblasts (require EPO), then erythroblasts, which synthesize hemoglobin and eject their nuclei to become reticulocytes.
Reticulocytes enter the bloodstream and mature into erythrocytes.


Erythrocyte Structure and Function
Erythrocytes are biconcave, anucleate cells specialized for gas transport. Their shape increases surface area for efficient gas exchange and flexibility for passage through capillaries. They lack most organelles and are essentially sacs of hemoglobin.
Life span: 100–120 days; destroyed in the spleen and liver.
Hemoglobin (Hb): The oxygen-carrying protein, composed of four polypeptide chains, each with a heme group containing iron (Fe2+).



Homeostatic Imbalances of Erythrocytes
Polycythemia
Polycythemia is an abnormal increase in RBC count, leading to increased blood viscosity and risk of thrombosis. Causes include bone marrow cancer (polycythemia vera) and adaptation to high altitudes (secondary polycythemia).
Anemia
Anemia is a decrease in the oxygen-carrying capacity of blood, due to reduced RBC count or abnormal/deficient hemoglobin.
Hemorrhagic anemia: Blood loss.
Pernicious anemia: Vitamin B12 deficiency.
Hemolytic anemia: RBC destruction.
Aplastic anemia: Bone marrow failure.
Iron-deficiency anemia: Inadequate iron intake or absorption.
Sickle cell anemia: Abnormal hemoglobin causes RBCs to sickle, leading to blockages and tissue damage.



Leukocytes (White Blood Cells)
Classification and Function
Leukocytes are the body's primary defense against infection. They are classified as granulocytes or agranulocytes based on the presence of cytoplasmic granules.
Granulocytes: Neutrophils, eosinophils, basophils
Agranulocytes: Lymphocytes, monocytes


Granulocytes
Neutrophils: Most abundant; phagocytize bacteria; multilobed nucleus.
Eosinophils: Combat parasitic infections; involved in allergic responses; bilobed nucleus.
Basophils: Release histamine and heparin; involved in inflammation; rarest WBC.
Agranulocytes
Lymphocytes: Large, round nucleus; B cells produce antibodies, T cells mediate cellular immunity.
Monocytes: Largest WBC; U- or kidney-shaped nucleus; become macrophages in tissues.
Leukopoiesis
Leukopoiesis is the formation of white blood cells from hematopoietic stem cells, regulated by colony-stimulating factors and interleukins.

Leukocyte Disorders
Leukocytosis: Elevated WBC count, often due to infection.
Leukopenia: Low WBC count, often due to drugs or disease.
Leukemia: Cancer of blood-forming tissues, leading to excessive, abnormal WBCs.
Platelets (Thrombocytes)
Structure and Function
Platelets are small, anucleate cell fragments derived from megakaryocytes. They play a critical role in hemostasis (blood clotting).
Contain granules with clotting factors and enzymes.
Normal count: 250,000–400,000 per mm3 of blood.


Hemostasis
Steps of Hemostasis
Hemostasis is the process that stops bleeding and involves five main steps:
Vascular spasm
Platelet plug formation
Coagulation (clotting cascade)
Clot retraction
Thrombolysis (clot removal)

Coagulation Cascade
Coagulation involves a complex cascade of reactions leading to the conversion of fibrinogen (soluble) to fibrin (insoluble), forming a stable blood clot. Key factors include prothrombin, thrombin, and calcium ions.
Clotting Disorders
Bleeding disorders: Hemophilia A (factor VIII deficiency), Hemophilia B (factor IX deficiency).
Hypercoagulable states: Thrombosis, deep vein thrombosis (DVT), pulmonary embolism.
Thrombus: Clot in an unbroken vessel; Embolus: Traveling clot that may block vessels elsewhere.
Anticlot Medications
Anticoagulants: Heparin, warfarin (Coumadin)
Antiplatelet drugs: Aspirin, clopidogrel
Thrombolytic agents: tPA, urokinase (used in stroke or heart attack)
Blood Groups and Transfusions
ABO Blood Group System
Blood types are determined by the presence or absence of antigens (A and B) on the surface of RBCs. The four main types are A, B, AB, and O.
Type A: A antigen; anti-B antibodies
Type B: B antigen; anti-A antibodies
Type AB: Both A and B antigens; no antibodies (universal recipient)
Type O: No antigens; both anti-A and anti-B antibodies (universal donor)
Rh Blood Group System
The Rh system is based on the presence (+) or absence (−) of the Rh antigen (D antigen). Rh incompatibility can cause hemolytic disease of the newborn if an Rh− mother carries an Rh+ fetus.
First exposure sensitizes the mother; subsequent pregnancies are at risk.
Prevention: Rho(D) immune globulin (RhoGAM) injection.
Blood Transfusion Reactions
Transfusion reactions occur if incompatible blood is transfused, leading to agglutination and hemolysis of donor RBCs. Proper blood typing and cross-matching are essential for safe transfusions.
Summary Table: Formed Elements of Blood
Cell Type | Description | Function |
|---|---|---|
Erythrocyte | Biconcave, anucleate; contains hemoglobin | Oxygen and carbon dioxide transport |
Neutrophil | Multilobed nucleus; fine granules | Phagocytosis of bacteria |
Eosinophil | Bilobed nucleus; red granules | Kill parasites, modulate allergies |
Basophil | S-shaped nucleus; dark granules | Release histamine, mediate inflammation |
Lymphocyte | Large, round nucleus | Immune response (antibody production, cellular immunity) |
Monocyte | U-shaped nucleus | Phagocytosis; become macrophages |
Platelet | Cell fragment | Blood clotting |
Additional info: This guide integrates textbook content, lecture notes, and academic context to provide a comprehensive overview of blood structure, function, and clinical relevance for anatomy and physiology students.
